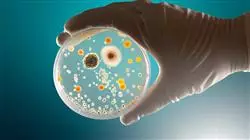
##IMAGE##

Universitäre Qualifikation
Die größte Fakultät für Pharmazie der Welt"
Präsentation
Dieser Universitätskurs bietet Ihnen die Möglichkeit, Ihr Wissen auf bequeme Art und Weise auf den neuesten Stand zu bringen, ohne dabei auf ein Höchstmaß an wissenschaftlicher Präzision zu verzichten, damit Sie die neuesten Fortschritte auf dem Gebiet der Infektionspathologie in Ihre tägliche pharmazeutische Praxis integrieren können”
Infektionskrankheiten sind nach wie vor die Hauptursache für Tod und Behinderung in der Welt. Im Jahr 2016 waren von den 56,4 Millionen Todesfällen weltweit 33% auf Infektionskrankheiten, 30% auf Herz-Kreislauf-Erkrankungen und 10% auf Krebs zurückzuführen. Der Kampf gegen Krankheiten wird an zwei Fronten gleichzeitig geführt: Infektionskrankheiten und chronische, nicht übertragbare Krankheiten.
Unter den 17,3 Millionen Menschen, die 2016 an Infektionen starben, waren die häufigsten Todesursachen Infektionen der unteren Atemwege (3,7 Millionen), Malaria (2,2 Millionen), Tuberkulose (1,3 Millionen), Durchfallerkrankungen (1,4 Millionen) und HIV/AIDS-Infektionen (1,1 Millionen). Die wichtigsten Faktoren, die im Zusammenhang mit Infektionskrankheiten zu berücksichtigen sind, sind Demografie, menschliches Verhalten, technologische, industrielle und wirtschaftliche Entwicklung sowie Veränderungen in der Flächennutzung, interkontinentaler Reiseverkehr und Handel, klimatische Veränderungen, die mikrobielle Anpassung selbst und schließlich das Verschwinden oder die Verringerung einiger wirksamer öffentlicher Gesundheitsmaßnahmen.
Diese interagierenden Faktoren haben dazu geführt, dass wir keinen Teil der Erde als mehr oder weniger isoliert vom Rest betrachten sollten. Auch das Auftreten, Wiederauftreten oder die Ausbreitung von eingeschleppten oder scheinbar ausgerotteten Infektionskrankheiten in unserer Umwelt ist nicht auszuschließen.
Die komplexe internationale epidemiologische Situation in diesem Jahrhundert, die durch die absichtliche Freisetzung von Bacillus Anthracis-Sporen, das Auftreten des West-Nil-Virus, das Schwere Akute Respiratorische Syndrom (SARS),
die zoonotische Verbreitung von Affenpocken, die Ebola-Epidemie, Fälle von Gelbfieber, Dengue und Cholera, das Auftreten neuer Arboviren wie Chikingunya und Zika, HIV/AIDS-Infektionen, Leptospirose, Tuberkulose, Lungenentzündung und die Zunahme neuer Arboviren wie Chikingunya und Zika und die Zunahme der Antibiotikaresistenz mit der Entwicklung multiresistenter Bakterien gekennzeichnet ist, machen deutlich, dass der Prozess der Fortbildung und Entwicklung des medizinischen Personals verbessert werden muss, wie es noch nie zuvor der Fall war.
Aktualisieren Sie Ihr Wissen über das Management von Infektionen und verbessern Sie Ihre berufliche Position als Pharmazeut"
Dieser Universitätskurs in Klinische Methode und Wissenschaftliche Untersuchung von Infektionskrankheiten enthält das vollständigste und aktuellste wissenschaftliche Programm auf dem Markt. Die wichtigsten Merkmale sind:
- Die Entwicklung von klinischen Fällen, die von Experten für die Klinische Methode und Wissenschaftliche Untersuchung von Infektionskrankheiten vorgestellt werden
- Der anschauliche, schematische und äußerst praxisnahe Inhalt vermittelt wissenschaftliche und gesundheitsbezogene Informationen zu den für die berufliche Praxis wesentlichen Disziplinen
- Neuigkeiten über Klinische Methoden und Wissenschaftliche Untersuchung von Infektionskrankheiten
- Er enthält praktische Übungen in denen der Selbstbewertungsprozess durchgeführt werden kann, um das Lernen zu verbessern
- Ein interaktives, auf Algorithmen basierende Lernsystem für die Entscheidungsfindung in klinischen Szenarien
- Theoretische Vorträge, Fragen an den Experten, Diskussionsforen zu kontroversen Themen und individuelle Reflexionsarbeit
- Die Verfügbarkeit des Zugriffs auf die Inhalte von jedem festen oder tragbaren Gerät mit Internetanschluss
TECH setzt ein Höchstmaß an wissenschaftlicher Präzision in diese Fortbildung mit dem Ziel, die angesehensten Pharmazeuten des Sektors zu qualifizieren"
Das Dozententeam besteht aus angesehenen und renommierten Fachleuten, die auf eine lange Karriere im Gesundheitswesen, in der Lehre und in der Forschung zurückblicken können. Sie haben in vielen Ländern auf mehreren Kontinenten
gearbeitet und dabei berufliche und pädagogische Erfahrungen gesammelt, die sie in außergewöhnlicher Weise in diesen Universitätskurs einbringen.
Das methodische Design dieses Programms, das von einem multidisziplinären Team von E-Learning-Experten entwickelt wurde, integriert die neuesten Fortschritte in der Bildungstechnologie, um zahlreiche multimediale Lernmaterialien zu erstellen, die es der Fachkraft ermöglichen, sich auf der Grundlage der Problemlösungsmethode mit der Lösung realer Probleme in ihrer täglichen klinischen Praxis zu befassen und so Fortschritte beim Erwerb von Wissen und bei der Entwicklung von Kompetenzen zu erzielen, die sich auf ihre zukünftige berufliche Tätigkeit auswirken.
Es ist anzumerken, dass alle erstellten Inhalte sowie die Videos, Selbsttests, klinischen Fälle und modularen Prüfungen von den Dozenten und dem Expertenteam, das die Arbeitsgruppe bildet, gründlich überprüft, aktualisiert und integriert wurden, um den Lernprozess auf didaktische und abgestufte Weise zu erleichtern, so dass die Ziele des Fortbildungsprogramms erreicht werden können.
Dies ist die Gelegenheit, die Sie schon lange gesucht haben, um sich als Apotheker weiterzuentwickeln und sich mit der klinischen Methode und der wissenschaftlichen Forschung im Bereich der Infektionskrankheiten vertraut zu machen"

Verpassen Sie nicht die Gelegenheit, sich über die Fortschritte bei der Behandlung von Infektionen zu informieren und diese in Ihre tägliche pharmazeutische Praxis einzubeziehen.
Warum bei TECH studieren?
TECH ist die größte digitale Universität der Welt. Mit einem beeindruckenden Katalog von über 14.000 Hochschulprogrammen, die in 11 Sprachen angeboten werden, ist sie mit einer Vermittlungsquote von 99% führend im Bereich der Beschäftigungsfähigkeit. Darüber hinaus verfügt sie über einen beeindruckenden Lehrkörper mit mehr als 6.000 Professoren von höchstem internationalem Prestige.

Studieren Sie an der größten digitalen Universität der Welt und sichern Sie sich Ihren beruflichen Erfolg. Die Zukunft beginnt bei TECH”
Die beste Online-Universität der Welt laut FORBES
Das renommierte, auf Wirtschaft und Finanzen spezialisierte Magazin Forbes hat TECH als „beste Online-Universität der Welt“ ausgezeichnet. Dies wurde kürzlich in einem Artikel in der digitalen Ausgabe des Magazins festgestellt, in dem die Erfolgsgeschichte dieser Einrichtung „dank ihres akademischen Angebots, der Auswahl ihrer Lehrkräfte und einer innovativen Lernmethode, die auf die Ausbildung der Fachkräfte der Zukunft abzielt“, hervorgehoben wird.
Eine disruptive Studienmethode, ein hochmoderner Lehrkörper und seine praktische Ausrichtung: der Schlüssel zum Erfolg der TECH.
Die umfassendsten Lehrpläne in der Universitätslandschaft
TECH bietet die vollständigsten Lehrpläne in der Universitätslandschaft an, mit Lehrplänen, die grundlegende Konzepte und gleichzeitig die wichtigsten wissenschaftlichen Fortschritte in ihren spezifischen wissenschaftlichen Bereichen abdecken. Darüber hinaus werden diese Programme ständig aktualisiert, um den Studenten die akademische Avantgarde und die gefragtesten beruflichen Kompetenzen zu garantieren. Auf diese Weise verschaffen die Abschlüsse der Universität ihren Absolventen einen bedeutenden Vorteil, um ihre Karriere erfolgreich voranzutreiben
TECH verfügt über die vollständigsten und intensivsten Lehrpläne im aktuellen Hochschulpanorama.
Die besten internationalen Top-Lehrkräfte
Der Lehrkörper der TECH besteht aus mehr als 6.000 Professoren von höchstem internationalen Ansehen. Professoren, Forscher und Führungskräfte multinationaler Unternehmen, darunter Isaiah Covington, Leistungstrainer der Boston Celtics, Magda Romanska, leitende Forscherin am Harvard MetaLAB, Ignacio Wistumba, Vorsitzender der Abteilung für translationale Molekularpathologie am MD Anderson Cancer Center, und D.W. Pine, Kreativdirektor des TIME Magazine, um nur einige zu nennen.
Zum Lehrkörper der TECH gehören Experten von internationalem Rang, die auf verschiedene Bereiche der Gesundheit, Technologie, Kommunikation und Wirtschaft spezialisiert sind.
Eine einzigartige Lernmethode
TECH ist die erste Universität, die Relearning in allen ihren Studiengängen einsetzt. Es handelt sich um die beste Online-Lernmethodik, die mit internationalen Qualitätszertifikaten renommierter Bildungseinrichtungen ausgezeichnet wurde. Darüber hinaus wird dieses disruptive akademische Modell durch die „Fallmethode“ ergänzt, wodurch eine einzigartige Online-Lehrstrategie entsteht. Es werden auch innovative Lehrmittel eingesetzt, darunter ausführliche Videos, Infografiken und interaktive Zusammenfassungen.
TECH kombiniert Relearning und die Fallmethode in allen ihren Hochschulprogrammen, um ein hervorragendes theoretisches und praktisches Studium zu gewährleisten, wann und wo immer Sie wollen.
Die größte digitale Universität der Welt
TECH ist die weltweit größte digitale Universität. Wir sind die größte Bildungseinrichtung mit dem besten und umfangreichsten digitalen Bildungskatalog, der zu 100% online ist und die meisten Wissensgebiete abdeckt. Wir bieten weltweit die größte Anzahl eigener Abschlüsse sowie offizieller Grund- und Aufbaustudiengänge an. Insgesamt sind wir mit mehr als 14.000 Hochschulabschlüssen in elf verschiedenen Sprachen die größte Bildungseinrichtung der Welt.
TECH verfügt über den umfangreichsten Katalog akademischer und offizieller Programme der Welt und bietet ihn in mehr als 11 Sprachen an.
Google Partner Premier
Der amerikanische Technologieriese hat TECH mit dem Logo Google Partner Premier ausgezeichnet. Diese Auszeichnung, die nur 3% der Unternehmen weltweit erhalten, unterstreicht die effiziente, flexible und angepasste Erfahrung, die diese Universität den Studenten bietet. Die Anerkennung bestätigt nicht nur die maximale Präzision, Leistung und Investition in die digitalen Infrastrukturen der TECH, sondern positioniert diese Universität auch als eines der modernsten Technologieunternehmen der Welt.
Google hat TECH durch die Verleihung des Logos Google Partner Premier in die Top 3% der weltweit führenden Technologieunternehmen aufgenommen.
Die offizielle Online-Universität der NBA
TECH ist die offizielle Online-Universität der NBA. Durch eine Vereinbarung mit der größten Basketball-Liga bietet sie ihren Studenten exklusive Universitätsprogramme sowie eine breite Palette von Bildungsressourcen, die sich auf das Geschäft der Liga und andere Bereiche der Sportindustrie konzentrieren. Jedes Programm hat einen einzigartig gestalteten Lehrplan und bietet außergewöhnliche Gastredner: Fachleute mit herausragendem Sporthintergrund, die ihr Fachwissen zu den wichtigsten Themen zur Verfügung stellen
TECH ist von der NBA, der weltweit führenden Basketball-Liga, als ihre offizielle Online-Universität anerkannt worden
Die von ihren Studenten am besten bewertete Universität
Die Studenten haben TECH auf den wichtigsten Bewertungsportalen als die am besten bewertete Universität der Welt eingestuft, mit einer Höchstbewertung von 4,9 von 5 Punkten, die aus mehr als 1.000 Bewertungen hervorgeht. Diese Ergebnisse festigen die Position der TECH als internationale Referenzuniversität und spiegeln die Exzellenz und die positiven Auswirkungen ihres Bildungsmodells wider
TECH ist die von ihren Studenten am besten bewertete Universität der Welt.
Führend in Beschäftigungsfähigkeit
TECH ist es gelungen, die führende Universität im Bereich der Beschäftigungsfähigkeit zu werden. 99% der Studenten finden innerhalb eines Jahres nach Abschluss eines Studiengangs der Universität einen Arbeitsplatz in dem von ihnen studierten Fachgebiet. Ähnlich viele erreichen einen unmittelbaren Karriereaufstieg. All dies ist einer Studienmethodik zu verdanken, die ihre Wirksamkeit auf den Erwerb praktischer Fähigkeiten stützt, die für die berufliche Entwicklung absolut notwendig sind.
99% der TECH-Absolventen finden innerhalb von knapp einem Jahr nach Abschluss ihres Studiums eine Anstellung.
Universitätskurs in Klinische Methode und Wissenschaftliche Untersuchung von Infektionskrankheiten
Global gesehen sind Infektionskrankheiten nach wie vor die Hauptursache für Sterblichkeit und Behinderung. In den letzten Jahren hat sich eine komplexe epidemiologische Situation entwickelt, zu der Bedrohungen wie Bioterrorismus, das Auftreten neuer und das Wiederauftreten anderer Krankheiten gehören. Darüber hinaus hat die Antibiotikaresistenz zur Entwicklung multiresistenter Bakterien geführt, was eine noch nie dagewesene Notwendigkeit geschaffen hat, die Ausbildung und Leistungsfähigkeit des pharmazeutischen Personals zu verbessern, um diesen Herausforderungen zu begegnen. Mit diesem Universitätskurs in Klinische Methode und Wissenschaftliche Untersuchung von Infektionskrankheiten haben Sie daher eine wertvolle Gelegenheit, Ihr Wissen in diesem Bereich auf den neuesten Stand zu bringen.
Erhalten Sie mit TECH aktuelle Informationen über das Verhalten von Infektionskrankheiten in der Bevölkerung
Mit dem Universitätskurs in Klinische Methode und Wissenschaftliche Untersuchung von Infektionskrankheiten werden Sie Ihre Fähigkeiten mit hochqualifizierten Experten im Umgang mit Infektionskrankheiten verfeinern. Dieses Programm bietet einen gründlichen und wissenschaftlichen Ansatz, um eine sorgfältige und aktuelle Vorbereitung auf die neuesten Techniken und Fortschritte im Bereich der Infektionskrankheiten aus einer pharmazeutischen Perspektive zu gewährleisten. Dies ist eine einzigartige Gelegenheit, sich in einem sich ständig weiterentwickelnden Sektor mit einer hohen Nachfrage nach hochqualifizierten Fachleuten hervorzuheben. Außerdem handelt es sich um ein 100%iges Online-Studium, das sich perfekt mit Ihren persönlichen oder beruflichen Verpflichtungen vereinbaren lässt, so dass Sie Ihre Studienzeiten nach eigenem Ermessen gestalten können.







